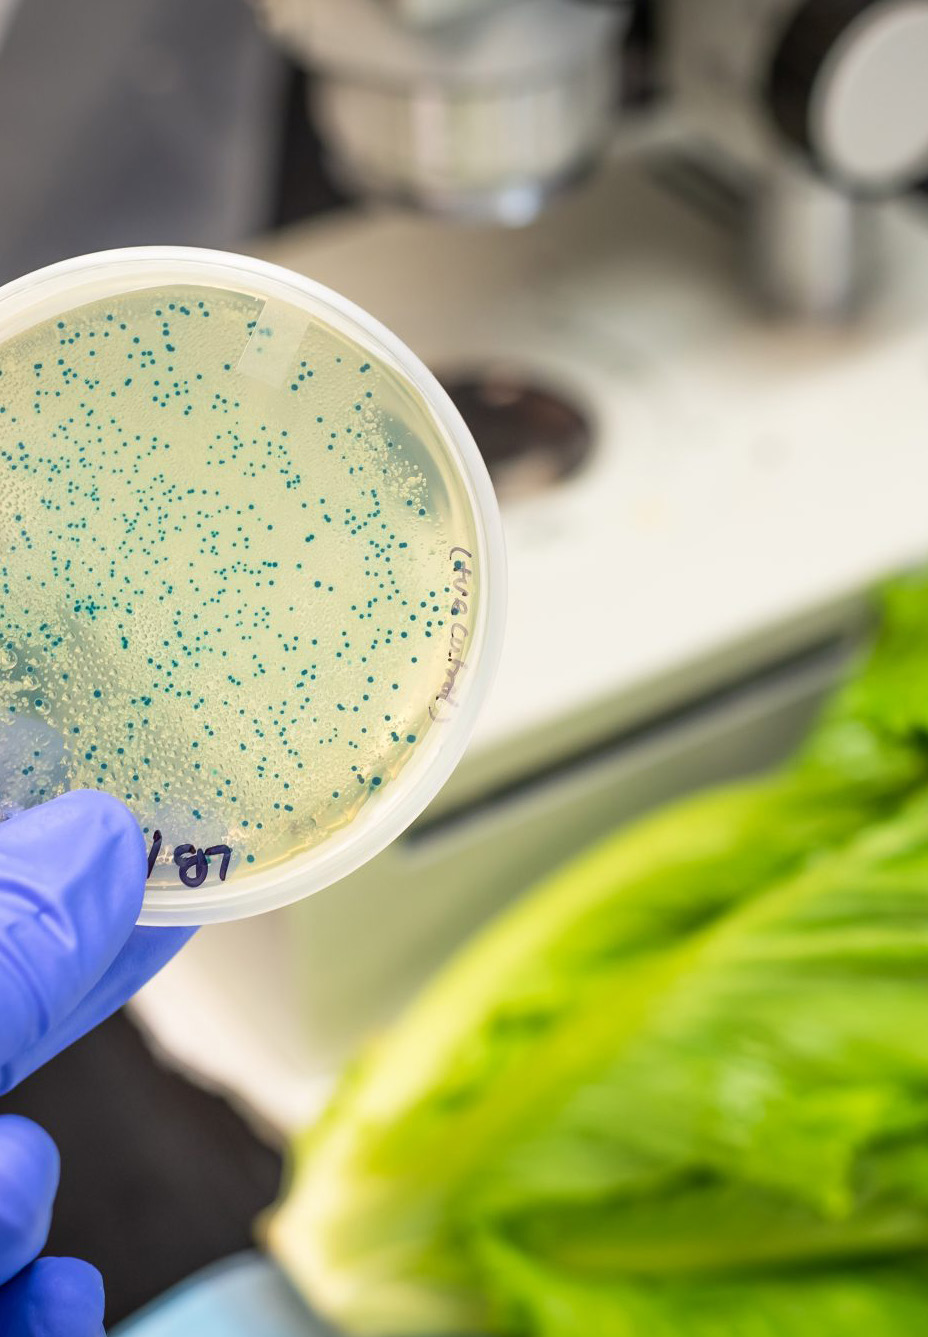

FSMA 7 Major Rules
Following the interest in the recent paper on the FDA Rule on traceability, over the coming months RQA and Perigon will provide a number of articles covering FDA’s Major Rules and other rules that support the implementation of the Food Safety Modernization Act (FSMA). This article focuses on the background to the development of FSMA and lists the Major Rules.
Introduction
The regulatory structure in the US is somewhat complex and confusing at times with different agencies covering different categories dependent on product category, product type and source. For example, the FDA regulates most seafood and the USDA regulates catfish, whereas the USDA regulates meat, but the FDA regulates game meat. Also, a pizza is regulated by the FDA unless it is topped with 2% or more of cooked meat or poultry, in which case it is USDA regulated!
Of course, in addition to food, the FDA also regulates cosmetics, human and animal drugs, tobacco products and other goods. Rules and guidance are published by the FDA to provide clarity on what the food industry is expected to do in order to comply with certain aspects of FSMA. The primary rules published initially were termed the “7 Major Rules”.
Foodborne illness and FSMA – from reactive to proactive
Typically, laws result from real world actions, incidents and data, and particularly where there are repeat or significant safety concerns. Back in the early 2010s, the Obama administration observed and acted upon CDC food borne pathogen data which showed that 1 in 6 Americans fall sick from food borne illness, of which a significant number require hospital treatment and around 3,000 go on to die each year.
This is not just a US problem, the World Health Organisation (WHO) estimated as many as 1 in 10 fall sick from foodborne illnesses globally each year with an estimated death toll of 420,000 in 2010. Not only are these largely preventable through proper good manufacturing practices and hygiene controls they also have a significant cost to the global economy. Sickness causes productivity losses due to time away from work as well as the potential need for expensive medical treatments, ongoing care and social support.
Given this situation the US government, along with relevant agencies, decided that largely avoidable health issues and their subsequent recalls needed a legislative push to implement strategies for positive change. The passing of the Food Safety Modernization Act (FSMA) enabled the FDA to better protect public health by strengthening food safety – switching focus to prevention rather than being simply a reactive organisation. It also strengthened the FDA’s implementation and enforcement authority (e.g. mandatory recalls). The FDA subsequently finalized 7 Major Rules in order to implement FSMA and these have been followed by other rules on specific elements of food safety along with guidance for industry.
FSMA Surveillance Working Group
In 2012, the Food Safety Modernization Act Surveillance Working Group (FSMA SWG) was formed. This group consists of 20 experts representing a cross-functional slice of the sector including local, state and federal governments, academia, industry and consumer groups4. One area of interest for the FSMA SWG Working Group has been their review of the challenges and opportunities of whole genome sequencing (WGS)5 for illness detection and response.
The 7 Major Rules
As mentioned above, the FDA finalized 7 strategic goals termed the “Foundational” or ‘Major Rules’ which have been incrementally developed and woven into guidance and legislation over recent years. These are:
Produce safety rule
This defines mandatory standards for growing, harvesting, packing, and holding of fresh produce. Including contamination protection requirements for water quality testing, raw manure application, examining grazing areas, employee health and hygiene training, and more.
Preventive controls for human food
Facilities must follow cGMP and implement a food safety plan that includes hazard analysis and risk-based preventive controls to minimize hazards. Facilities that have identified a hazard requiring a preventive control must also have a recall plan.
Preventive controls for animal food
Facilities must follow cGMP and implement a food safety plan that includes hazard analysis and risk-based preventive controls to minimize hazards. Facilities that have identified a hazard requiring a preventive control must also have a recall plan.
Foreign Supplier Verification Programs (FSVP)
Importers must perform certain risk-based activities to verify that food imported into the U.S. is produced in compliance with FDA regulatory requirements. This includes things like supplier approval and performance evaluations to determine risks and potential hazards associated.
Accreditation of third-party auditors/certification bodies
This is a voluntary program for the accreditation of third-party certification bodies that will conduct food safety audits and issue certifications for foreign facilities and the food they produce.
Sanitary transportation of human and animal food
A mandatory requirement for shippers, receivers, loaders, and carriers that transport food in the U.S. to ensure food safety. This relates to ‘farm to fork’ control of safety, maintaining proper temperature controls and preventing contamination throughout the logistics processes.
Mitigation Strategies to Protect Food Against Intentional Adulteration
The aim of this rule is to prevent acts of intentional adulteration that can potentially cause harm to public health. It creates a mandatory requirement for all food facilities to develop and implement a detailed food defence plan covering the entire process end to end (farm to fork).
When is a Final Rule not a Major Rule?
Further final rules have been added since the 7 Major Rules were finalized, including the recent Final Rule on traceability (issued 2022), the Final Rule on laboratory accreditation for analyses of food (issued 2021) and the rule on agricultural water (issued 2022). All of these issue dates come with a defined grace period giving time to comply, or as the FDA put it “educate before and while we regulate”. Naturally other rules are still able to be developed and some are at the “proposed” stage.
But what is the difference between a Major Rule, a Rule and a Final Rule? The 7 Major Rules were issued in 2015 and 2016. The additional “Final” Rules added later assist with further implementation of FSMA. For clarity, a rule is initially a “proposed rule” until it becomes a “Final Rule”. This is the last step of the rulemaking process in which the agency responds to public comment on the proposed rule and makes appropriate revisions before publishing the Final Rule in the Federal Register to become effective.
In future issues of this article series we will further discuss the 7 Major Rules.

Summary
The FDA have taken a pragmatic approach to reduce levels of risk proactively. The practical focus and ethos of the 7 Major Rules of FSMA strive to drive a proactive approach versus the more traditional reactive one throughout the industry. As the agency says “FDA has finalized 7 Major Rules to implement FSMA, recognizing that ensuring the safety of the food supply is a shared responsibility among many different points in the global supply chain for both human and animal food. The FSMA rules are designed to make clear specific actions that must be taken at each of these points to prevent contamination”.
RQA can assist:
Training courses:
- Intentional Adulteration Conducting Vulnerability Assessments
- Preventive Controls Qualified Individual (PCQI) for human food
- Preventive Controls Qualified Individual (PCQI) for animal food
- Foreign Supplier Verification Program (FSVP)

